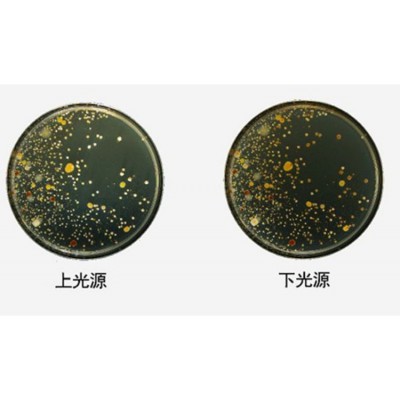

產品介紹
LB-6300 型便攜式全自動菌落計數儀,由圖像采集系統和菌落分析軟件構
成,均有菌落統計、特征檢測及描述功能,適用于生物醫療、檢測防疫、疾 病控
制、質量監督、環境監測、食品衛生、以及大專院校、研究院所等領域的微生物
菌落分析和科學研究。
產品特點
1. 工業平板電腦,觸摸操作使用方便;
2. 便攜式操作,配置可移動的培養皿支架;
3. 采用攝像頭方式對培養皿進行計數取代了傳統的技數方式,更加的高效方
便;
4. 本儀器采用平板電腦自帶的 500 萬像素攝像頭,通過銳化、濾波等方法
對圖像進行優化,同時可以手動調整計數的參數范圍等;
5. 自動切去培養皿周邊圖像,圖像更清晰;
6. 自動標記每一個被計數的菌落;
7. 具有查看歷史圖片的功能,圖片在計數完成后手動保存在內部存儲中,通過
“歷史數據”功能即可查看圖片記錄;
8. 歷史數據方便輸出擴展到 EXCEL 以及“history”文件夾,方便進一步分析
或記錄等項目操作;
9. 全中文菜單,操作簡單易懂。

技術參數
1.平板尺寸:10 寸,便于攜帶,輕便!
2.鏡頭分辨率:500 萬
3.硬盤空間:120G
4.內存:12G
5.可檢測最小菌落:0.5mm
6.計數:手動控制全自動計數
7.圓形培養皿直徑:75mm 培養皿、90mm 培養皿(其他小號的培養皿在拍攝
時請盡量放在光圈的中央)
8.誤差率:<±10%
9.操作系統:Windows10
10.屏幕分辨率:1920×1200
?

 手機企騰網工廠優選|
手機企騰網工廠優選|